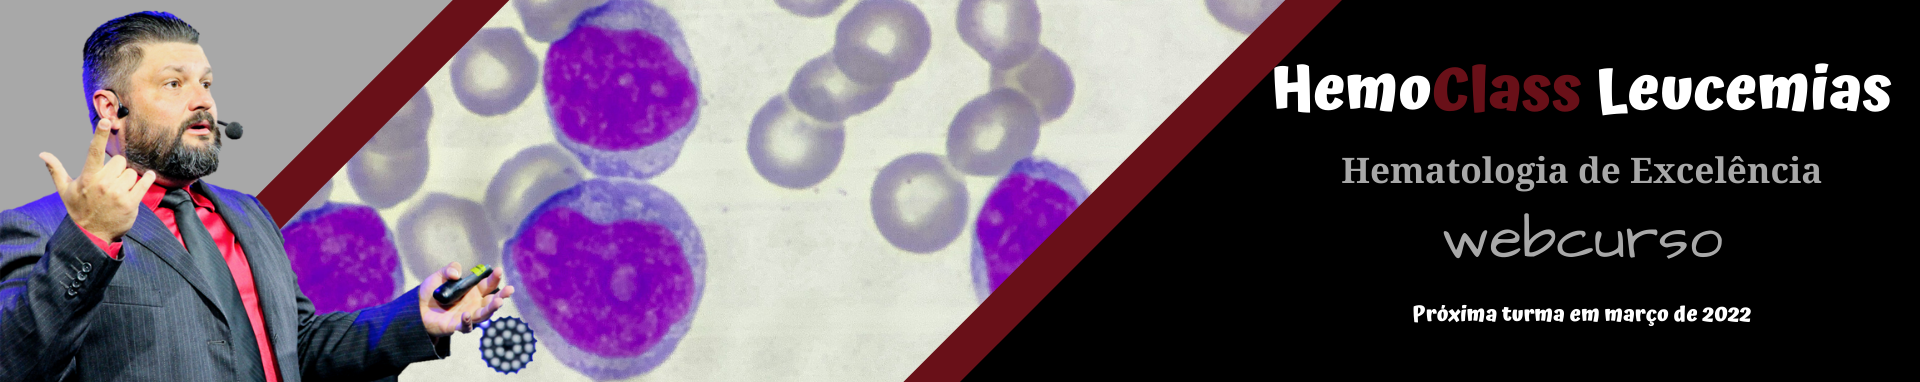

Conheça nossos Cursos
Conheça nossos Cursos
-

HemoClass - HC - Entendendo a Hemostasia e Interpretando o Coagulograma
É um curso voltado para profissionais que dependem de realizar ou interpretar os exames de coagulação em sua ...
-

Análise CrÃtica do Leucograma e Padronizações Morfológicas
A dúvida entre linfócitos normais ou reativos, entre pró-mielócito ou mielócito, entre tantas outras. O que seria granulação tóxica? ...
-

Hematologia Pratica
Este curso é direcionado para profissionais de Análises Clínicas e acadêmicos que almejam a excelência em hematologia. O curso ...
-

Análise Critica Anemias e Seus Exames Complementares - Teórico/Prático
Este curso é realizado de maneira teórica, com aula expositiva/interativa sobre a eritropoiese e fisiologia das hemácias e ...
-

Leucemias - Fisiopatologia e Diagnóstico Laboratorial
Um dos cursos mais solicitados da HemoClass. Leva o acadêmico para dentro da realidade microscópica das leucemias, com ...
-

Coleta e Processamento de Amostras
Descrição: Este curso pode ser somente teórico, ou teórico com prática incluída. Trata-se de um curso/treinamento de acordo com ...
-
png.png)
Hemato 21
Se você precisa melhorar nas alterações de rotina de hematologia, adequar a forma de liberar o hemograma e ...
-

HemoClass - HC - Hemostasia e Coagulação
Este curso é voltado para profissionais que dependem de realizar ou interpretar os exames de coagulação em sua ...
-

Novas Alterações Citomorfológicas da Hematologia
Pare de travar quando aparece “aquela célula estranha” na lâmina. Em 2 horas, você vai aprender a reconhecer novas ...
-

Hematologia Prática
Seu Guia Definitivo para realizar um hemograma PRECISO e IMPECÁVEL Torne-se um especialista indispensável em seu laboratório e acelere ...
-

HemoClass Leucemias um treinamento de VERDADE
Este curso é voltado para profissionais que fazem hematologia de bancada e pretendem saber mais sobre as leucemias. Como ...
 Blog HemoClass
Blog HemoClass
png.jpg)
Linfócito reativo em crianças: por que é um achado normal (e como interpretar sem pânico)
O que é um linfócito reativo?
É um linfócito que “ganhou corpo” após ativação antígeno–anticorpo. Essa ativação leva a alterações morfológicas (citoplasma mais amplo e basofílico, contorno irregular, às vezes nucléolo evidente) e funcionais (produção de anticorpos, citocinas etc.). Em outras palavras: é o linfócito fazendo o seu trabalho.
Por que aparecem tanto em crianças?
-
Exposição constante a antígenos novos: cada vacina, infecção banal e contato ambiental apresenta “novos cartões de visita” ao sistema imune.
-
Maturação imunológica acelerada: nos primeiros anos, há uma verdadeira “academia” para linfócitos B e T.
-
Janela etária típica: do nascimento até ~3,5–4 anos, é comum ver LR no esfregaço.
Resumo prático: em pediatria, encontrar LR é normal e esperado. Um hemograma de uma criança de ~2 anos completamente “estéreo” de LR pode, inclusive, levantar sobrancelhas — sempre dentro do contexto clínico.
Como interpretar no hemograma
1) Não olhar só para a contagem total
LR podem aparecer com leucócitos normais. “Só libero LR quando há leucocitose” é um erro. Contexto é rei: quadro clínico, diferencial leucocitário, morfologia.
2) Valor absoluto vs. percentual
Relate percentual e, quando possível, o valor absoluto. Pequenos percentuais em amostras com linfocitose típica da infância ainda são condizentes com fisiologia.
3) Descrição morfológica ajuda o clínico
Se o laboratório utiliza microscopia, vale caracterizar brevemente (p. ex.: “linfócitos com citoplasma basofílico amplo, contorno irregular, compatíveis com reatividade”). Evite termos alarmistas.
Quando o LR não é só fisiologia? (sinais de alerta)
Embora raro, há contextos que pedem atenção e correlação clínica:
-
Citopenias associadas (anemia, trombocitopenia relevantes)
-
Aparência atípica não compatível com reatividade usual (suspeita de blastos)
-
Sintomas sistêmicos importantes (perda ponderal, febre prolongada, sangramentos, linfonodomegalias exuberantes)
-
Padrões persistentes e desproporcionais sem explicação clínica (ex.: LR altos por longos períodos, fora de infecções/vacinas)
Nesses cenários, o caminho é discutir com o pediatra, considerar repetição do exame, revisão do esfregaço e, se indicado, investigação direcionada.
Erros comuns (e como evitá-los)
-
Nunca “liberar” LR em crianças
Errado. Em crianças pequenas, LR são comuns. Omiti-los prejudica a leitura do caso.
-
Só “liberar” LR quando há leucocitose
Errado. LR podem aparecer com leucócitos normais. O achado é morfológico/funcional, não depende da contagem total.
-
Laudo genérico, sem contexto
Melhor: incluir observações curtas e úteis (“achado compatível com faixa etária/reatividade imunológica”, “correlacionar com quadro clínico”).
Boas práticas para laboratórios e profissionais
-
Padronize critérios de identificação e relato de LR (checklists morfológicos ajudam).
-
Comunique “sem drama”: use linguagem clara e educativa no comentário do laudo.
-
Integre com a clínica: se houver sinal de alerta, destaque e sugira correlação/seguimento.
-
Eduque pais/cuidadores: quando houver contato direto, explique que LR é, na maioria, “sinal de defesa”, não de gravidade.
Exemplo de comentário de laudo (sugestão):
“Presença de linfócitos reativos, achado comum na faixa etária pediátrica e compatível com resposta imune. Correlacionar com quadro clínico. Sem outras atipias relevantes no esfregaço.”
Para pais e cuidadores: uma explicação simples
“Linfócito reativo” significa que células de defesa do seu filho foram ativadas — geralmente por contato com vírus, bactérias, vacinas ou outros estímulos normais nesta fase da vida. Na grande maioria dos casos, não é motivo de pânico. O médico avalia o resultado junto com os sintomas e com o restante do exame.
Perguntas frequentes (FAQ)
1) LR é sinal de infecção grave?
Na maioria das vezes, não. É um marcador de resposta imune, comum em resfriados, pós-vacina e outras exposições benignas.
2) Precisa repetir o hemograma por causa de LR?
Depende do contexto. Se a criança está bem e o restante do hemograma está ok, geralmente não.
3) LR vira “câncer de sangue”?
LR não são blastos. São células maduras ativadas. Preocupações com hematopatias surgem por conjunto de achados (morfologia suspeita, citopenias, clínica), não por LR isolado.
4) Existe “valor normal” de LR?
Relata-se presença e percentual; não há um “valor de referência” universal — o importante é a interpretação contextual (idade, clínica, demais parâmetros).
Principais aprendizados
-
Em crianças (RN → ~4 anos), linfócito reativo = achado esperado.
-
Não condicione o relato de LR à presença de leucocitose.
-
Descreva e contextualize: ajuda o pediatra e evita alarmes desnecessários.
-
Fique atento aos sinais de alerta para diferenciar reatividade fisiológica de situações que pedem investigação.
No HemoClass LAN você entenderá DEFINITIVAMENTE as alterações hematológicas com base na fisiopatologia de cada alteração/processo.
O LAN é disparado a MELHOR FORMAÇÃO em hematologia do mercado!
png.jpg)
Howell Jolly Like em Neutrófilos
1) O que são
Inclusões citoplasmáticas arredondadas, pequenas, fortemente basofílicas (roxo‑escuro) em neutrófilos, que lembram visualmente os corpos de Howell‑Jolly dos eritrócitos. Estudos com coloração fluorescente (p.ex., DAPI) confirmam natureza DNA‑positiva (fragmentos nucleares).
Importante: não confundir com corpos de Howell‑Jolly em hemácias (marcadores de hipo/asplenia). As HJLI ocorrem em neutrófilos e estão ligadas principalmente a imunossupressão e granulopoiese estressada/displásica.
2) Características morfológicas (como reconhecer)
-
Formato/contorno: esférico a oval, bem delimitado.
-
Tamanho: pequeno (tipicamente < grânulo tóxico; semelhante ou um pouco maior que um ponto de cromatina).
-
Cor: basofílica intensa em colorações tipo Romanowsky (roxo escuro).
-
Número/posição: geralmente única por célula, localizada no citoplasma; pode haver raras múltiplas.
-
Células acometidas: predominantemente neutrófilos segmentados e bastonetes.
Dicas práticas
-
Aumente para imersão (100×) para avaliar contorno nítido e cor homogênea.
-
Se disponível, contraste com Döhle (azul‑claro mal delimitado) e com mórulas de Anaplasma/Ehrlichia (aglomerados múltiplos, maiores, aspecto “saco de uvas”).
3) Diagnóstico diferencial rápido
| Achado | Localização | Cor/aspecto | Dicas diferenciais |
|---|---|---|---|
| HJLI (neutrófilo) | Citoplasma | Ponto roxo‑escuro, redondo, bem nítido | Geralmente único; DNA‑positivo; associação com imunossupressão/terapia |
| Döhle | Citoplasma | Mancha azul‑pálida, mal definida | ER rugoso; costuma vir com toxicidade (grânulos tóxicos, vacúolos) |
| Mórula (Anaplasma/Ehrlichia) | Citoplasma | Aglomerado de grânulos finos | Várias “bolinhas” juntas; quadro febril/leucopenia plausível |
| Corpúsculo de Barr | Núcleo (apêndice) | “Drumstick” ligado à cromatina | Visto em mulheres; é apêndice nuclear, não inclusão citoplasmática |
4) Como reportar no laudo
Campo: Morfologia leucocitária / observações
-
Modelo 1 (achado discreto): “Inclusões tipo Howell‑Jolly em neutrófilos, raras.”
-
Modelo 2 (achado significativo): “Inclusões tipo Howell‑Jolly em neutrófilos: ocasionais a frequentes. Achado descrito em pacientes imunossuprimidos (p.ex., pós‑transplante, HIV, quimioterapia) e em granulopoiese displásica; correlacionar com quadro clínico/terapêutico.”
-
Quantificação sugerida (opcional): classificar como raras (<1/100 neutrófilos), ocasionais (1–5/100), frequentes (>5/100), conforme contagem estimada em 200 leucócitos.
-
Quando acrescentar comentário: se novo no prontuário, se numerosas, ou se não há histórico de imunossupressão conhecido.
Exemplo de comentário curto:
“As inclusões observadas têm morfologia compatível com Howell‑Jolly‑like em neutrófilos, descritas em contextos de imunossupressão (p.ex., antivirais análogos de nucleosídeos, tacrolimo, quimioterapia), infecções virais e displasia granulocítica. Sugerimos correlação com medicações, histórico de transplante/HIV e achados clínico‑laboratoriais associados.”
5) Significado clínico e associações descritas
-
Imunossupressão: pós‑transplante sólido ou de células‑tronco; uso de tacrolimo/calcineurínicos, quimioterapia.
-
Antivirais (análogos de nucleosídeos) e terapia antirretroviral.
-
HIV/AIDS e infecções virais (ex.: relatos em COVID‑19).
-
Síndromes mielodisplásicas (SMD) e granulopoiese estressada/displásica.
Interpretação: achado inespecífico, porém sinalizador de contexto clínico. Não confere, por si, diagnóstico etiológico ou prognóstico independente; deve ser interpretado junto a história, medicações e demais alterações morfológicas (p.ex., pseudo‑Pelger, grânulos tóxicos).
6) Recomendações operacionais para o laboratório
-
Confirmar em imersão e por dupla leitura quando possível.
-
Registrar e graduar (rara/ocasional/frequente) no LIS.
-
Verificar histórico no pedido/prontuário: transplante, HIV, quimioterapia, antivirais/imunossupressores.
-
Sugerir correlação clínica no laudo quando achado for novo ou proeminente.
-
Em suspeita clínica de anaplasmose/ehrlichiose (febre, citopenias, exposição a carrapato), alertar o médico e considerar testes específicos.
7) Ilustrações (para treinamento interno)
-
Exemplos de HJLI em neutrófilos (banco de imagens hematológicas em materiais didáticos do serviço).
-
Painel comparativo com Döhle, mórulas e corpúsculo de Barr.
8) Nota de educação continuada
Este informativo sintetiza evidências de relatos de caso, séries e revisões recentes. O fenômeno é raro, porém relevante em populações imunossuprimidas. Manter a equipe treinada para não confundir com inclusões infecciosas ou alterações nucleares fisiológicas (Barr).

Alterações Hematológicas no Uso Crônico de Ãlcool: Causas, Diagnóstico e Apoio Laboratorial
Alterações Hematológicas no Uso Crônico de Álcool: Como Identificar e Interpretar no Laboratório
Na rotina de um laboratório clínico, não é incomum receber hemogramas com alterações que, à primeira vista, parecem não ter explicação. Trombocitopenia repentina, pancitopenia sem causa aparente, anemias incomuns — tudo isso pode levantar dúvidas e atrasar a liberação de resultados.
Em muitos desses casos, um fator comum aparece quando investigamos mais a fundo: o uso crônico de álcool.
Por que o uso crônico de álcool altera o hemograma?
O etanol exerce múltiplos efeitos nocivos sobre o sistema hematológico, e compreender esses mecanismos é essencial para evitar erros interpretativos:
-
Toxicidade medular: o álcool afeta diretamente a medula óssea, reduzindo a produção de eritrócitos, leucócitos e plaquetas, levando à pancitopenia periférica.
-
Deficiências nutricionais: compromete a absorção de vitaminas essenciais à hematopoese. A falta de vitamina B12 e ácido fólico causa anemia megaloblástica, enquanto a deficiência de vitamina B6 leva à anemia sideroblástica.
-
Síndrome de Zieve: caracterizada por anemia hemolítica, icterícia e hiperlipidemia, geralmente associada à deficiência de vitamina E e alterações na membrana eritrocitária.
-
Trombocitopenia alcoólica: pode ocorrer pela redução da trombopoietina hepática ou pelo hiperesplenismo decorrente de hipertensão portal em hepatopatias alcoólicas.
-
Apoptose plaquetária: o álcool pode induzir morte celular precoce nas plaquetas, aumentando o risco de sangramento.
-
Imunidade comprometida: o uso crônico prejudica a função de neutrófilos e macrófagos, elevando a suscetibilidade a infecções.
A importância da interpretação correta no laboratório
Nem sempre o prontuário do paciente traz informações claras sobre histórico de etilismo. Muitas vezes, o analista clínico precisa suspeitar do uso crônico de álcool a partir dos padrões hematológicos observados e buscar exames complementares para confirmar.
Uma interpretação segura depende de:
-
Correlação entre achados hematológicos e bioquímicos;
-
Conhecimento atualizado sobre mecanismos fisiopatológicos;
-
Atenção aos sinais indiretos no hemograma.
Quando buscar apoio especializado?
Casos complexos exigem decisões rápidas e embasadas. Ter acesso a uma assessoria remota em hematologia significa contar com suporte técnico imediato para discutir resultados, orientar investigações adicionais e padronizar laudos.
Esse suporte é especialmente valioso quando:
-
O hemograma apresenta alterações múltiplas e atípicas;
-
Há suspeita de condições como Síndrome de Zieve ou anemia sideroblástica;
-
O histórico clínico é incompleto ou inexistente.
Com esse tipo de parceria, o laboratório aumenta sua assertividade, reduz erros interpretativos e entrega mais valor para médicos e pacientes.
📌 Sua equipe pode interpretar hemogramas complexos com muito mais segurança. Conheça como nossa assessoria remota pode integrar conhecimento técnico-laboratorial à sua rotina e elevar a qualidade dos seus resultados.
Nos contate clicando AQUI para saber mais sobre o serviço de assessoria remota!
Texto produzido por Flavio Simplicio Maia - Assessor HemoClass
 Conheça nossos Serviços
Conheça nossos Serviços
-

Treinamentos in loco
Capacite seu pessoal no próprio ambiente de trabalho, verificando quais fatores podem ser aproveitados e quais podem ser ...
-

Produção de Informes Médicos
Já fez as adequações recomendadas em seu laboratório e não sabe como transmitir isso de maneira informativa ao ...
-

Treinamento in Loco em Coleta SanguÃnea e Processamento de Amostras
Atualmente é consenso que os processos pré-analíticos são responsáveis pela detenção de 70% dos erros dos exames laboratoriais. Geralmente ...
-

Assessoria Laboratorial Remota
- Dúvidas na hora de liberar um hemograma? O que liberar? O que não liberar? - E aquela célula ...
-

Venda de Lâminas Permanentes
A comparação visual é a melhor forma para se aprender hematologia prática. Não somente com atlas e livros, ...
-

Consultoria
Tenha suporte técnico científico para seu laboratório e realize seus exames de acordo com padronizações e convenções internacionais. A ...
-

Assessoria Médica
Conte com um suporte 24h para interpretação de exames hematológicos de seus pacientes via watsapp. Este serviço é exclusivo ...
png.png)



png.jpg)



